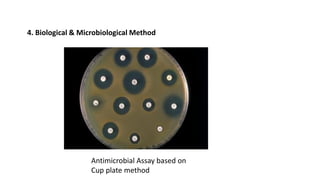
4. Biological & Microbiological Method
Antimicrobial Assay based on
Cup plate method

The document provides an introduction to pharmaceutical analysis, discussing topics like volumetric analysis, the scope of pharmaceutical analysis, classification of quantitative analysis methods, and sources of error. Primary standards like benzoic acid and secondary standards prepared in the lab are used to standardize solutions. Various methods like titration, spectroscopy, and chromatography are used in pharmaceutical analysis.